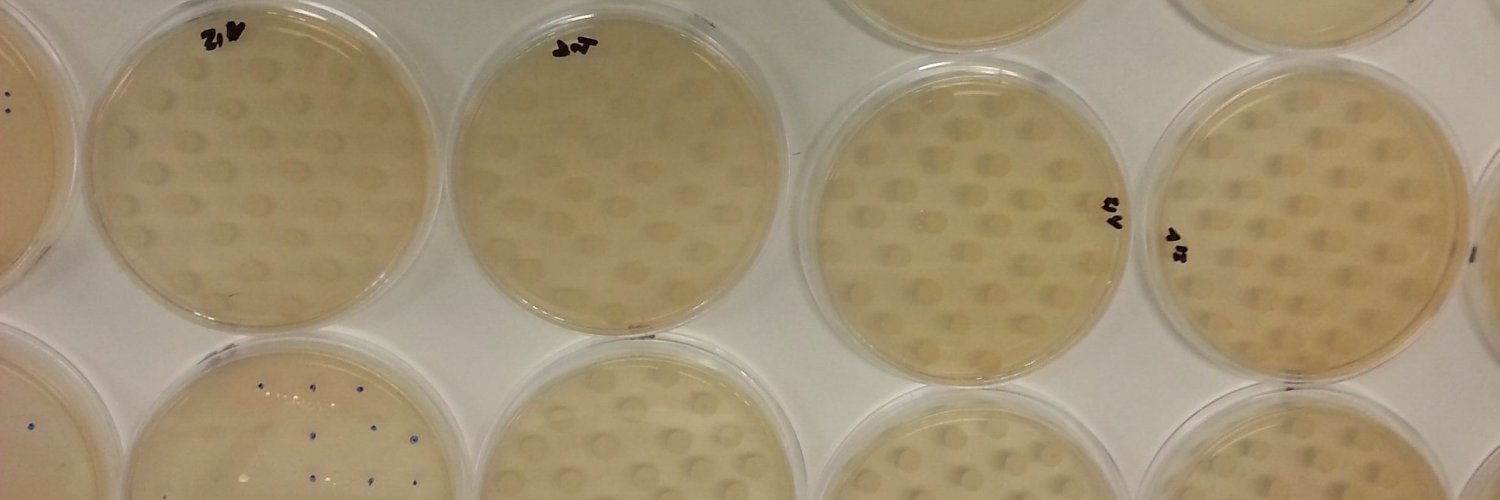
Aaron Heffernan banner

Aaron Heffernan
698 posts

Aaron Heffernan
@Critcare_bear
Junior doctor, PhD candidate, pharmacist - interested in all things sepsis
Brisbane, Queensland Katılım Aralık 2015
1.1K Takip Edilen351 Takipçiler
Aaron Heffernan retweetledi

CRE RESPOND AMO Seminar Obese Patients - our first speaker, Jack Cross, is currently speaking on "Antibacterial dosing in obesity - clinical cases". #UQCCR @jasonroberts_pk @GileadSciences @pfizer @UQPharmacy @ABsteward @UQMedicine


English
Aaron Heffernan retweetledi

Join us tomorrow at AMO Obese Patients seminar to hear about optimising antibacterial & antifungal dosing with Chair, Dr Hafiz Abdul-Aziz & speakers Jack Cross & Haifa Lyster. Register: bit.ly/3Ois2oA
#UQCCR @jasonroberts_pk @HaifaLyster @CHUNimes @pfizer @GileadSciences
GIF
English

@TPP_MD The wool series is a must read for any fan of the dystopia genre.
English

Going to the beach today. Need an audible/audio book for the 4 hour drive there and back.
Categories I like: business, self-improvement, dystopian, and “who done it”
Ready? Go!
#books #booklover #beachtrip
English

So thrilled to have passed my PhD viva today! 🥳 Huge thanks to @cathymac40 and David Laight for rigorous discussion - I know where ‘PhD defence’ comes from now!
Massive thanks @DrAnnaReed @jasonroberts_pk Kevin Watts Jeremy mills and @paulrutter10 for supervision & mentorship!


English

@Critcare_bear @ABsteward @Inox94 No.
The inclusion criterion of “required new antibiotic treatment with meropenem by clinician assessment” resulted in the enrollment of primarily patients with hospital-acquired sepsis at randomization.
English

🔥🆕️MERCY RCT🆕️🔥
Continuous administration of meropenem, compared with intermittent administration, does NOT improve clinically relevant outcomes in critically ill patients with sepsis. #IDTwitter
jamanetwork.com/journals/jama/…

English
Aaron Heffernan retweetledi

Nurses save lives.
I see this all the time in the ICU.
It's a curious thing - both obvious, yet also frequently overlooked.
🙏Thank you for everything that you do.
#NursesWeek




English

Such a good book. Many lessons that can be applied in the context of clinical decision making for medicine and patient care.
Annie Duke@AnnieDuke
Thinking in Bets: Zoom AMA February 20th annieduke.substack.com/p/zoom-ama-feb…
English

@DoverMarian @RACGPPresident @PharmGuildAus @Dom_Perrottet And why do GPs want to dispense? This one I have no idea a out because dispensing is time consuming and challenging. I can understand in remote areas where there is no pharmacy, but otherwise this seems to detract from medical care rather than enhance due to the added pressures.
English

@DoverMarian @RACGPPresident @PharmGuildAus @Dom_Perrottet The question we should be asking is why pharmacists think they should prescribe? I suspect it has more to do with the difficulties in accessing a GP in a timely manner, which is frustrating for patient and pharmacist alike.
English

Practicing at "the top of your scope" means embedding yourself in the multidisciplinary team. Rather than fight for my ability to dispense medications as a GP, I want pharmacists working within the team.
@RACGPPresident @PharmGuildAus @Dom_Perrottet
English
Aaron Heffernan retweetledi

#CCPLU Highlights
Continuous enteral nutrition leading to less continuous BMs? This @Crit_Care trial found ↑ risk of constipation with continuous EN compared to intermittent feeds, & no other significant differences in ADE’s #PharmICU @Critcare_bear loom.ly/gPaYhuI
English

It is a journey that only ends when you stop. One must enjoy the journey and not just the end product (consultancy) - the end product is more training.
The Emergency Mind Project@TheEmergMind
Let go of the idea that your training will ever be complete. Let go of the idea that you will ever be “finished.” Just keep training.
English
Aaron Heffernan retweetledi
Aaron Heffernan retweetledi

Just like the Queensland trial, this is a recipe for disaster. I urge the NSW Government in the strongest possible terms not to expand the scope of pharmacists to allow them to prescribe antibiotics. Patient safety and wellbeing is at stake. #PatientCare dailytelegraph.com.au/news/nsw/nsw-p…
English

@HannahKWebster1 @DavidKuICUMelb So true. Any AWS issues there?
English

